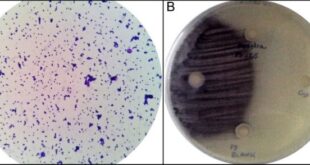

Actividad se realizó especialmente para los egresados de la carrera y abordó temáticas de alto interés para los profesionales.
Más informaciónGobernador electo de Valparaíso visitó Centro de Investigación HUB Ambiental de la UPLA
Rodrigo Mundaca conoció las líneas de trabajo de este polo científico orientado a la conservación y preservación de ecosistemas terrestres y acuáticos, coincidiendo con uno de los ejes centrales de su gestión.
Más informaciónEquipo PACE UPLA participa en Primer Encuentro IES PACE Región de Coquimbo
El encuentro generó un espacio de reflexión, diálogo e intercambio de experiencias de las instituciones de educación superior en el contexto del Programa PACE.
Más informaciónLos íconos patrimoniales del Valle del Aconcagua. Quinta parte: Rutas y caminos patrimoniales de la primera sección
Columna del geógrafo y profesor de la Facultad de Ciencias Naturales y Exactas, Gastón Gaete Coddou, publicada en diario El Trabajo de San Felipe, el miércoles 16 de junio de 2021.
Más informaciónVinculación con el Medio UPLA firmó tres importantes alianzas estratégicas en pro de la conexión con el entorno de la región de Valparaíso
A través de su Unidad de Relaciones Institucionales, la DGVM busca articular vínculos colaborativos con agentes territoriales locales.
Más información¿Hace ayunos prolongados? Cuidado! saltarse comidas afecta el metabolismo y la concentración
Nutricionistas UPLA en último año de formación, enfatizan que mantener horarios regulares de comida permite que el organismo conserve un nivel constante de glucosa, energía y peso.
Más informaciónLos caminos de Claudio Puga: Entre la docencia y el arbitraje profesional
El profesor de Educación Física titulado en la Universidad de Playa Ancha en 1994, y árbitro profesional de fútbol desde 1995, conversó con los estudiantes de primero y quinto año de la carrera.
Más informaciónNuevos hallazgos sobre Piscirickettsia salmonis y herramientas para su diagnóstico molecular
Académico de la Universidad de Playa Ancha, Dr. Héctor Levipan, junto a investigadores de universidades chilenas aportan información sobre bacteria patógena causante de una de las principales enfermedades infecciosas de la industria salmonera.
Más informaciónEl impacto del cambio climático en los riesgos naturales costeros: El ejemplo de Quebec, Canadá
La conferencia será dictada por el geógrafo y académico de la Universidad de Quebec, Dr. Guillaume Marie, el jueves 17 de junio, a las 15 horas, por plataforma Zoom.
Más información«Desafíos RecreActivos» la nueva propuesta de la DIDER UPLA
Para este mes la invitación es a recorrer 15 kilómetros en bicicleta o reemplazarlo por 10 kilómetros de trote o 5 de caminata.
Más información UPLA.cl
UPLA.cl Noticias de la Universidad de Playa Ancha Dirección General de Comunicaciones
Noticias de la Universidad de Playa Ancha Dirección General de Comunicaciones